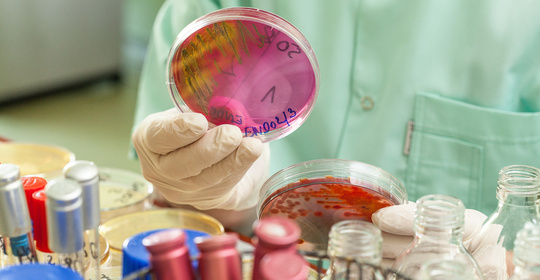

本文介紹了乾眼症可能導致角膜病變,並著重強調了角膜受傷後的處理措施。由於乾眼症涉及多種可能的影響因素,對於具體治療方法的選擇應由專業醫生進行評估。

本文介紹了酒精性周圍神經病變的診斷要點和酒精性腦病的病變機制。酒精性周圍神經病變的診斷要點包括:患者有長期飲酒史,出現感覺減退或消失、肌力下降、運動協調障礙等症狀;體格檢查顯示深反射減弱或消失,可伴有肌肉萎縮;血液中酒精濃度測定有助於排除其他原因引起的神經系統疾病。

本文介紹了脆的鐵線蕨及其與鞭葉鐵線蕨的區別,指出脆的鐵線蕨的葉片質地較薄且易折斷,而鞭葉鐵線蕨則具有獨特的葉片形態、波浪狀葉緣、長而粗壯的葉柄、翠綠明亮的葉色以及圓形的孢子囊群等特徵。若觀察到植物的特性與所述不符或存在異常,建議尋求園藝專家或植物學家協助鑑別。

本文介紹了分泌物過多的情況,指出其可能與濕邪有關,並提及了多種可能導致這種情況出現的原因,包括不同的婦科疾病以及荷爾蒙紊亂引起的內分泌失調。在診斷出具體原因後,針對病因進行治療是非常重要的。因此,如果遇到分泌物過多的問題,應儘快就醫以獲得專業的評估和治療建議。

本文介紹了頸椎病變的相關原因以及診斷方法。該疾病可能由多種因素引起,如椎間盤退行性變、頸椎骨質增生等,也可能與先天性畸形有關。針對不同病因導致的症狀,其治療方法也有所不同。因此,在面對頸椎病變時,應首先明確具體原因,並在專業醫生指導下選擇合適的治療方案。

本文介紹了頸脊髓病變後遺症的治療方法,包括物理療法、功能鍛鍊、矯形器使用、針灸治療、神經電刺激等;並強調了若症狀無改善或加重時應及時就醫。該疾病涉及多種治療方法,因此在選擇科室就診時,可考慮骨科、康復醫學科、神經內科、疼痛科、針灸推拿科等。

本文介紹了頸椎病的原因和症狀,強調了早期診斷和治療的重要性。該疾病可能由多種因素引起,如年齡、外傷、先天畸形等,並且其症狀多樣,從輕微的頸部不適到嚴重的行動受限。因此,當出現相關症狀時,應及時就醫以便獲得準確的診斷和適當的治療。

本文強調了類澱粉病變可能導致的症狀,並指出該疾病涉及多系統時應儘快就醫以便進行準確診斷與治療。類澱粉神經病變變的診斷需考慮其特有的臨床表現及影像學特徵。

本文介紹了類澱粉神經病變變的潛在病因及治療方式。該疾病涉及神經細胞中異常積累的蛋白沉積物,這些蛋白主要包括tau蛋白和朊蛋白。由於其複雜的病理機制,建議患者在出現相關症狀時尋求專業醫療幫助以制定有效的管理策略。

糖尿病視網膜病變中期,通常是指非增殖期視網膜病變。一般情況下,該疾病多考慮是長期血糖控制不佳引起的,也不排除是高血壓、高脂血症等原因導致的。

本文介紹了女性聲音低沉的原因以及可能涉及的相關疾病,如聲帶腫脹、甲狀腺功能減退、庫欣症候群、慢性支氣管炎、喉返神經傷害等,並強調了針對具體原因進行針對性治療的重要性。建議患者在出現聲音低沉的症狀時及時就醫,以便進行準確的診斷並接受適當的治療。

本文介紹了白質病變與失智的關係。白質是大腦中負責傳遞神經訊號的區域,其病變可能導致神經訊號傳導受阻,進而干擾正常的認知功能,提高患失智的風險。白質病變所致失智的原因各異,可能與多發性硬化症、阿茲海默症、路易體癡呆、額顳葉癡呆以及帕金森病癡呆有關。

本文指出失智症與輕度腦白質病變可能存在關聯,並強調了兩者之間的關係。該病症可能導致認知功能障礙、運動協調缺陷等表現,鑑於其與多種疾病相關性,建議患者及時就醫以明確診斷並接受相應治療。

本文介紹了糖尿病腎病的診斷與治療。該疾病需要綜合考慮血糖控制、血壓管理、飲食療法、胰島素治療、腎臟替代療法等多種措施進行干預。若症狀沒有改善或者加重,應立即尋求醫療幫助。

本文介紹了糖尿病皮膚病變的原因和表現。糖尿病皮膚病變是由於長期高血糖引起微血管病變和神經病變變所致,主要症狀有瘙癢、皮疹、水腫等。糖尿病的其他常見症狀還包括多尿、口渴、疲乏、體重下降、視力模糊等。若患者出現上述症狀,應及時就醫進行確診和治療。

本文介紹了糖尿病的病理機制和診斷方法。糖尿病可能因胰島素抵抗、胰島β細胞功能缺陷等原因引起,導致血糖水平持續升高。該疾病涉及多種病因學因素,因此建議患者在面對疑似症狀時應儘快尋求專業醫生的幫助以制定適當的治療方案。

本文介紹了紅斑性病變的診斷與治療。該疾病可能涉及多種方法進行管理,如皮膚活檢、區域性類固醇藥物(Corticosteroids)注射、口服免疫調節劑、光療治療、生物製劑治療等。若症狀沒有改善或者加重,應立即尋求醫療幫助。